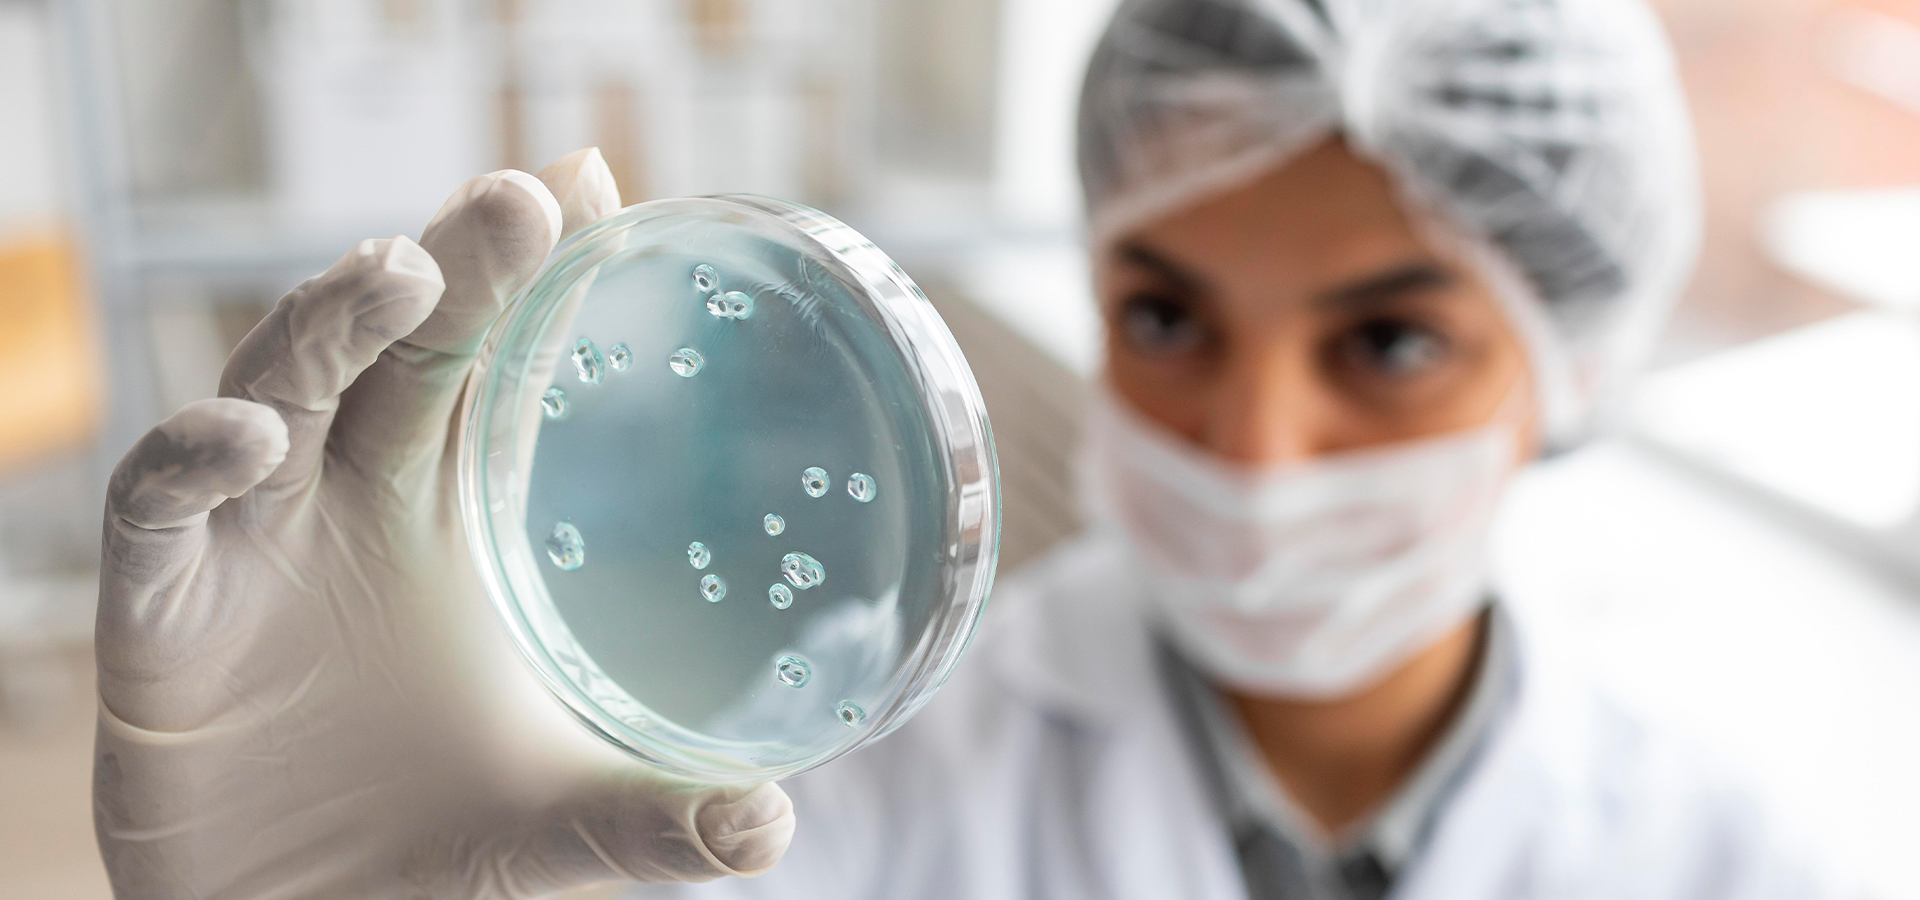
Farmacologia Clínica: Microbiologia, Imunologia e Quimioterapia

Farmacologia Clínica: Microbiologia, Imunologia e Quimioterapia
30 horas
2 meses
30 horas (2 meses)
Curso que reforça segurança e decisão terapêutica.
Pular para as informações do produto
Preencha seus dados
Preço normal
R$
110,00
/mês
Diferenciais do Curso
Aprenda princípios da farmacologia usados em tratamentos clínicos.
Certificado
Todos os cursos possuem certificado de conclusão.
Aplicação Clínica
Farmacodinâmica
Farmacocinética
Áreas de Atuação
Áreas de atuação
Conheça mais sobre os cursos
O que você vai aprender
Cursos Livres